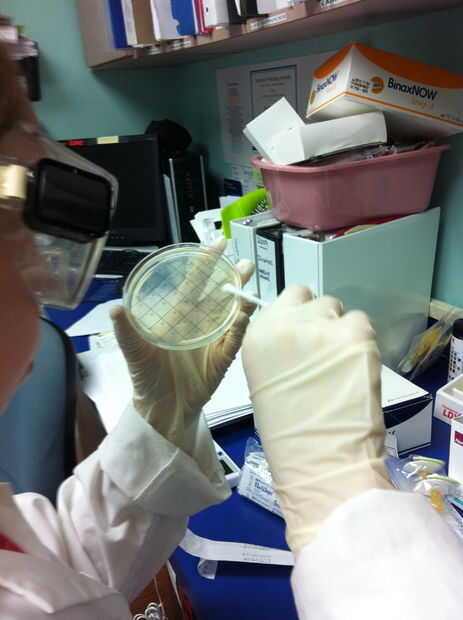
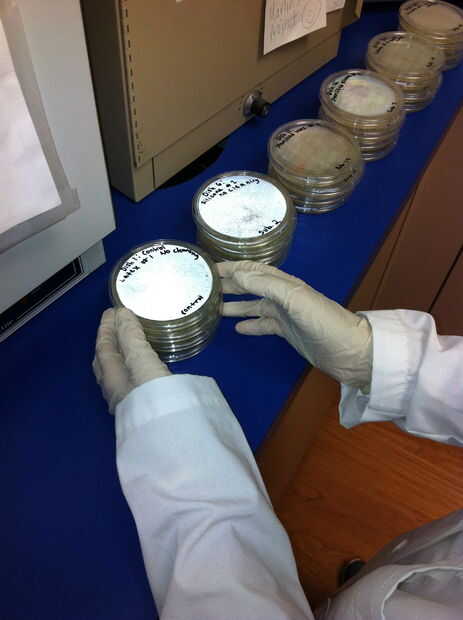
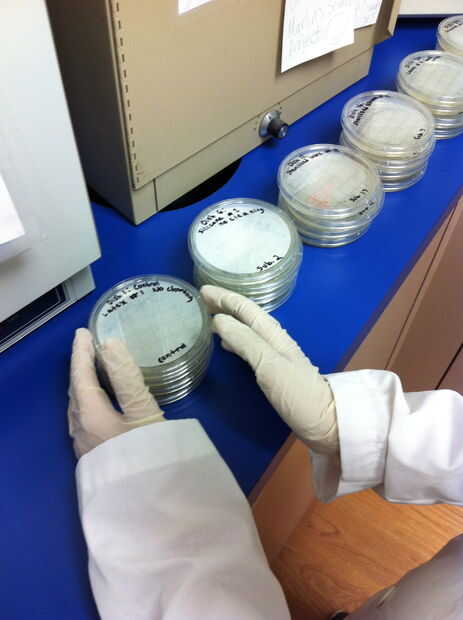

Paso 5: Procedimiento (traté de ser tan exhaustiva como sea posible. Ser preparado - es muy largo)

PARTE 1
1)-desarrollar plan de investigación y visita centros para determinar ubicaciones de parques infantiles.
2)-consultar con el director científico y de laboratorio calificado en un laboratorio certificado con respecto a la recogida de muestras adecuadas, los procedimientos y seguridad.
3)-investigar sobre las marcas y tipos de chupetes que están disponibles para su compra. Crear una hoja de cálculo con información sobre las marcas de chupetes, identificar características, y si son de látex o de silicona.
4)-si es necesario, presentar plan de investigación para su aprobación al director científico y de laboratorio calificado.
5)-plan de 2 días para recoger chupetes en 2 diferentes mall infantiles.
6)-comprar aproximadamente 24 chupete nuevo (12 silicona y látex 12).
7)-el primer día, ir a un centro comercial con microbiólogo calificado.
8)-18 recoger chupetes (silicona de látex y 9 9). Seguir recoger chupetes hasta que se obtienen los números apropiados.
9)-traer tazas de colección de orina células estériles, bolsas estériles, guantes, un marcador permanente negro y 24 chupetes nuevos.
10)-ubicar el centro comercial Parque.
11)-Colóquese guantes.
12)-encontrar a padres con un niño con un chupete.
13)-para eliminar el riesgo si eres un estudiante investigador, tiene un supervisor designado acercarse a los padres y cortésmente les pregunte si les gustaría participar en este proyecto para tratar de determinar si los chupetes de látex o de silicona albergan las bacterias menos.
- un)-Asegúrese de que el niño es asintomático en la actualidad y se podría clasificar como un "bebé sano".
- b)-también hacer Asegúrese de que el niño es de 2 años de edad o más jóvenes. Chupetes sólo será recogidas de los niños de ese grupo de edad con el fin de restringir el común de la flora microbiana encontrada en un "bebé" y así probable ser encontrado en los chupetes en el estudio.
14)-si te dicen que sí, tiene firme el formulario de formulario/encuesta de consentimiento informado para donantes de chupete y completar la encuesta.
15)-escribe en Copa/bolsa "Látex" si el chupete es látex o escribir "Silicona" si el chupete es silicona. También escriba el número del sujeto en la taza o bolsa para que coincida con la forma con el chupete.
16)-dar participante un chupete nuevo para sustituir a la antigua (de silicona o látex dependiendo del tipo donado para el proyecto).
17)-Abra la taza o bolsa para el chupete.
18)-ha puesto participante utilizado chupete en bolsa/taza.
19)-cerrar la bolsa/recipiente estéril.
20)-retirar guantes y desechar en el contenedor de basura del centro comercial.
21)-poner en un nuevo par de guantes.
22)-Repita los pasos 11-20 con 17 padres adicionales y chupetes (o los padres adicionales si no se recoge el número correcto de chupetes de cada tipo).
23)-poner látex todos sellados tazas de bolsas en dos bolsas grandes de almacenamiento de Ziploc.
24)-etiqueta estas bolsas "Chupetes de látex".
25)-obtener dos bolsas Ziploc más.
26)-etiqueta de esta bolsa "Chupetes de silicona."
27)-puso todos los chupetes de silicona en los bolsos.
PARTE 2 (realizado en el laboratorio)
28)-viaje con científico calificado al laboratorio.
29)-se preparan para hacer el trabajo de laboratorio poner pelo, colocarle una bata, lavarse las manos, ponerse gafas de seguridad y poniendo en guantes de látex estériles.
30)-4 chupetes de látex (1 control unsucked, 3 aspirado) y 4 chupetes de silicona (1 control unsucked, 3 aspirado) de la muestra con un hisopo estéril. Frote la cabeza de la esponja en el pezón del chupete. Poner en un nuevo par de guantes entre cada muestreo para prevenir la contaminación cruzada.
31)-Coloque hisopos en envase estéril.
32)-obtener y etiqueta 8 platos de petri preparadas usando el marcador negro permanente.
- un) - plato 1 - "Control - chupete de Latex #1 no limpieza"
- b) - plato 2 - "chupete de Latex #2 no limpieza"
- c) Antena 3 - "chupete de Latex #3 no limpieza"
- -plato 4 - d) "chupete de Latex #4 no limpieza"
- e) - plato 5 - "Control - chupete de silicona # 1 no limpieza"
- f) - plato 6 - "chupete de silicona #2 no limpieza"
- g) - plato 7 - "chupete de silicona #3 no limpieza"
- h) - plato 8 - "chupete de silicona #4 no limpieza"
33)-poner dulce par de guantes.
34)-Retire la torunda muestra paquete y transferencia a agar en el plato 1 arrastrando el hisopo en el agar varias veces mientras se hace girar la torunda.
35)-use cinta para sellar cajas Petri (no abrir). Traer terminados placas de Petri a incubadora.
36)-Coloque los platos en los estantes en incubadora de 37 grados centígrados.
37)-incubar durante 48 horas.
38)-el día dos, si suficientes especímenes no fueron obtenidos (9 de cada tipo - látex, silicona), viajan a un centro comercial diferente con microbiólogo calificado.
39)-Repita los pasos 7-27 en el segundo sitio de la colección (si es necesario). Si se obtienen especímenes adicionales, repita los pasos 28-38 en el laboratorio antes de pasar al paso 40.
40)-aproximadamente 48 horas después de comenzar la incubación, viajar con científico calificado al laboratorio.
41)-se preparan para hacer el trabajo de laboratorio poner pelo, colocarle una bata, lavarse las manos, ponerse gafas de seguridad y poniendo en guantes de látex estériles.
42) uno por uno, retire cuidadosamente sellado cajas Petri de incubadora sin quitar la tapa.
43)-tienda en refrigerador a 6 grados centígrados.
PARTE 3 (realizada en laboratorio)
44)-disponer de guantes y ponga un nuevo par.
45)-obtener una cacerola de 3 cuartos limpios.
46)-llenar con 1 cuarto de galón de agua destilada.
47)-poner el agua a hervir en la hornilla portátil en laboratorio.
48)-tomar un chupete de látex en una taza de orina bolsa y pone el chupete en agua hirviendo durante 5 minutos. Cuidadosamente sumerja el chupete en agua.
49)-después de 5 minutos, cuidadosamente saque el chupete de agua el uso de pinzas de metal y coloque en una bolsa estéril fresca.
50) - repetir pasos 46 - 49 con los tres más chupetes látex y silicona (1 unsucked y 3 aspirado de cada tipo).
51)-Apague la estufa de quemadores.
52)-vierta agua en la olla por el desagüe en el laboratorio.
53)-abrir un paquete de hisopo y tomar un hisopo estéril.
54)-cada uno de los 8 chupetes esterilizados (control unsucked 1 y 3 chupetes aspirados de cada tipo) muestra frotando la cabeza de la esponja en el chupete.
55)-volver cada hisopo al paquete.
56)-devolver cada chupete en bolsa estéril y ponerlo al lado.
57)-obtener y etiqueta 8 placas de Petri
- un) - plato 9 - "Control - chupete látex esterilizado #1".
- b) - plato 10 - "esterilizado latex chupete #2."
- c) plato 11 - "Chupete látex esterilizado #3."
- d) - plato 12 - "esterilizado latex chupete #4."
- e) - plato 13 - "Control - chupete silicona esterilizada #1".
- f) - plato 14 - "esterilizado silicona chupete #2."
- g) - plato 15 - "esterilizado silicona chupon #3."
- h) - plato 16 - "esterilizado silicona chupete #4."
58)-poner dulce par de guantes.
59)-obtener plato 9 - "Control - chupete látex esterilizado # 1".
60)-sacar un chupete de látex, unsucked que fue esterilizado.
61)-transferencia de la muestra y agar en plato 9 arrastrando el hisopo en el agar varias veces mientras se hace girar la torunda.
62)-disponer de esponja en la bolsa de desechos médicos.
63)-Repita los pasos usando 58-62 platos 10-16.
64)-disponer de guantes y ponga un nuevo par.
65)-use cinta para sellar cajas Petri (no abrir). Una vez preparados todos los platos de petri, poner 8 platos en incubadora durante 48 horas a una temperatura de 37 grados centígrados.
66 años)-debidamente disponer de guantes, tazas y bolsas que los chupetes eran en (en bolsas de eliminación de residuos médicos de laboratorio).
67)-después de 48 horas, viajar con científico calificado al laboratorio.
68)-se preparan para hacer el trabajo de laboratorio poner pelo, colocarle una bata, lavarse las manos, ponerse gafas de seguridad y poniendo en guantes de látex estériles.
69)-cuidadosamente Remueva los platos de petri sellados 8 de incubadora sin quitar las tapas.
70)-tienda en refrigerador a 6 grados centígrados (ahora platos 1-16 están en el refrigerador).
PARTE 4 (realizado en el laboratorio)
71)-disponer de guantes y ponga un nuevo par.
72)-obtener y etiqueta 8 platos de petri preparadas usando el marcador negro permanente.
- un) - plato 17 - "Control - lavada a mano Latex chupete #1"
- b) - plato 18 - "Latex chupete #2 mano"
- plato c) 19 - "Latex chupete #3 mano lavada"
- d) - plato 20 - "Latex chupete #4 lavada a mano"
- -plato 21 - e) "Control - lavada a mano chupete # 1 silicona"
- f) - plato 22 - "silicona chupete #2 mano"
- g) - plato 23 - "silicona chupon #3 lavada a mano"
- -plato de 24 - h) "silicona chupete #4 lavada a mano"
73)-mueva los platos al lado.
74)-obtener un control, chupete látex unsucked.
75)-lavar el chupete con agua caliente, con jabón líquido para platos, 5 segundos.
76)-obtener una toalla de papel y seco el chupete.
77)-hisopo estéril abierto en paquete.
78)-muestra el chupete látex frotando la cabeza de la esponja en el pezón del chupete.
79)-ponga chupete látex en Copa/bolsa y póngalo al lado.
80)-transferencia de la muestra y agar en plato 17 arrastrando el hisopo en el agar varias veces mientras se hace girar la torunda.
81)-ponga la tapa sobre el plato y sellar con cinta adhesiva (no abrir).
82)-mover plato 17 al lado.
83)-disponer de esponja en la bolsa de desechos médicos.
84)-disponer de guantes y ponga un nuevo par.
85)-Repita los pasos del 74-84 con platos 18-24, con el tipo de muestra adecuada o el control.
86)-disponer de todos los chupetes muestreados en la bolsa de desechos médicos.
87)-una vez que se inoculan todos los platos, cuidadosamente, uno por uno, transferir todos 8 platos sellados a la incubadora durante 48 horas a una temperatura de 37 grados centígrados.
88)-después de 48 horas, viajar con científico calificado al laboratorio.
89)-se preparan para hacer el trabajo de laboratorio poner pelo, colocarle una bata, lavarse las manos, ponerse gafas de seguridad y poniendo en guantes de látex estériles.
90)-cuidadosamente Remueva los platos de petri sellados 8 de incubadora sin quitar las tapas.
91)-tienda en refrigerador a 6 grados centígrados (ahora platos 1-24 están en el refrigerador).
PARTE 5 (llevado a cabo en el laboratorio)
92)-viaje con científico calificado al laboratorio.
93)-se preparan para hacer el trabajo de laboratorio poner pelo, colocarle una bata, lavarse las manos, ponerse gafas de seguridad y poniendo en guantes de látex estériles.
94)-quitar platos 1-24 de refrigerador.
95)-plato de transferencia 1 para mesa de laboratorio.
96)-buscar en la caja Petri, mantenerlo cerrado y sellado. Contar todas las colonias de bacterias utilizando las líneas de cuadrícula en la caja Petri. Registro. Calcular el porcentaje de cuadrículas ocupadas por crecimiento microbiano en el plato.
97)-registrar observaciones adicionales en relación con el aspecto del plato sellado.
98)-trate de determinar los tipos de bacterias en el plato utilizando Manual de Bergey para identificación de bacterias.
99)-registrar observaciones adicionales.
100)-Repita los pasos del 95-99 con platos 2-24.
101)-cuando grabar observaciones para todas las muestras, selle la bolsa de residuos y deja en el laboratorio para la eliminación adecuada.
102)-los medios de cada uno de 6 conjuntos de datos (3 métodos de tratamiento diferentes a cada uno de 2 diferentes tipos de chupetes), se analizará mediante la preparación de una pantalla de histograma del número de colonias presentes en cada uno de los conjuntos de datos 6.